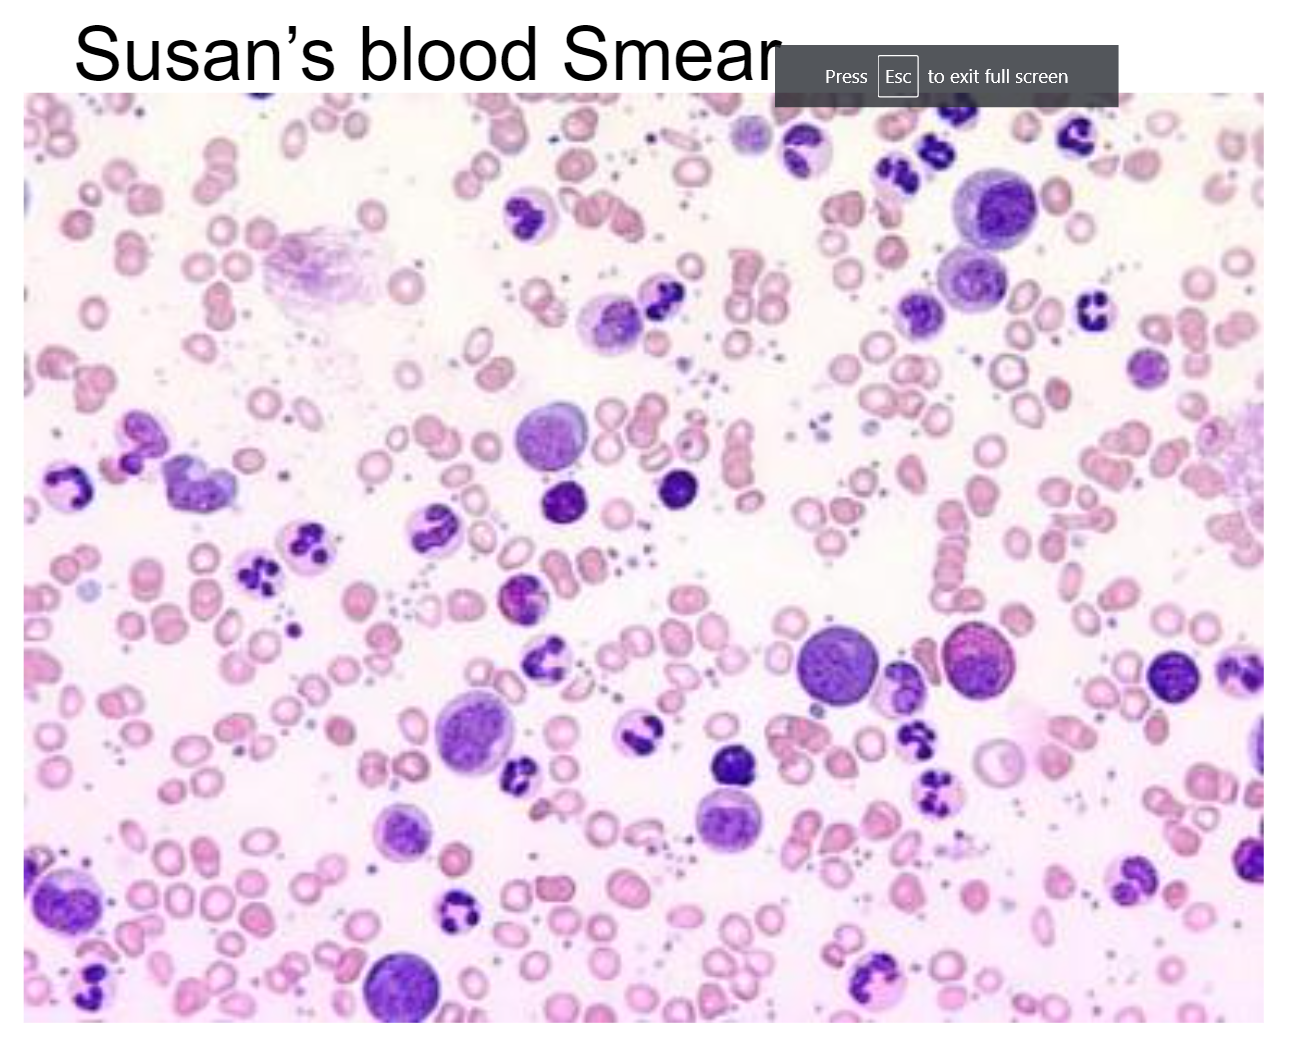
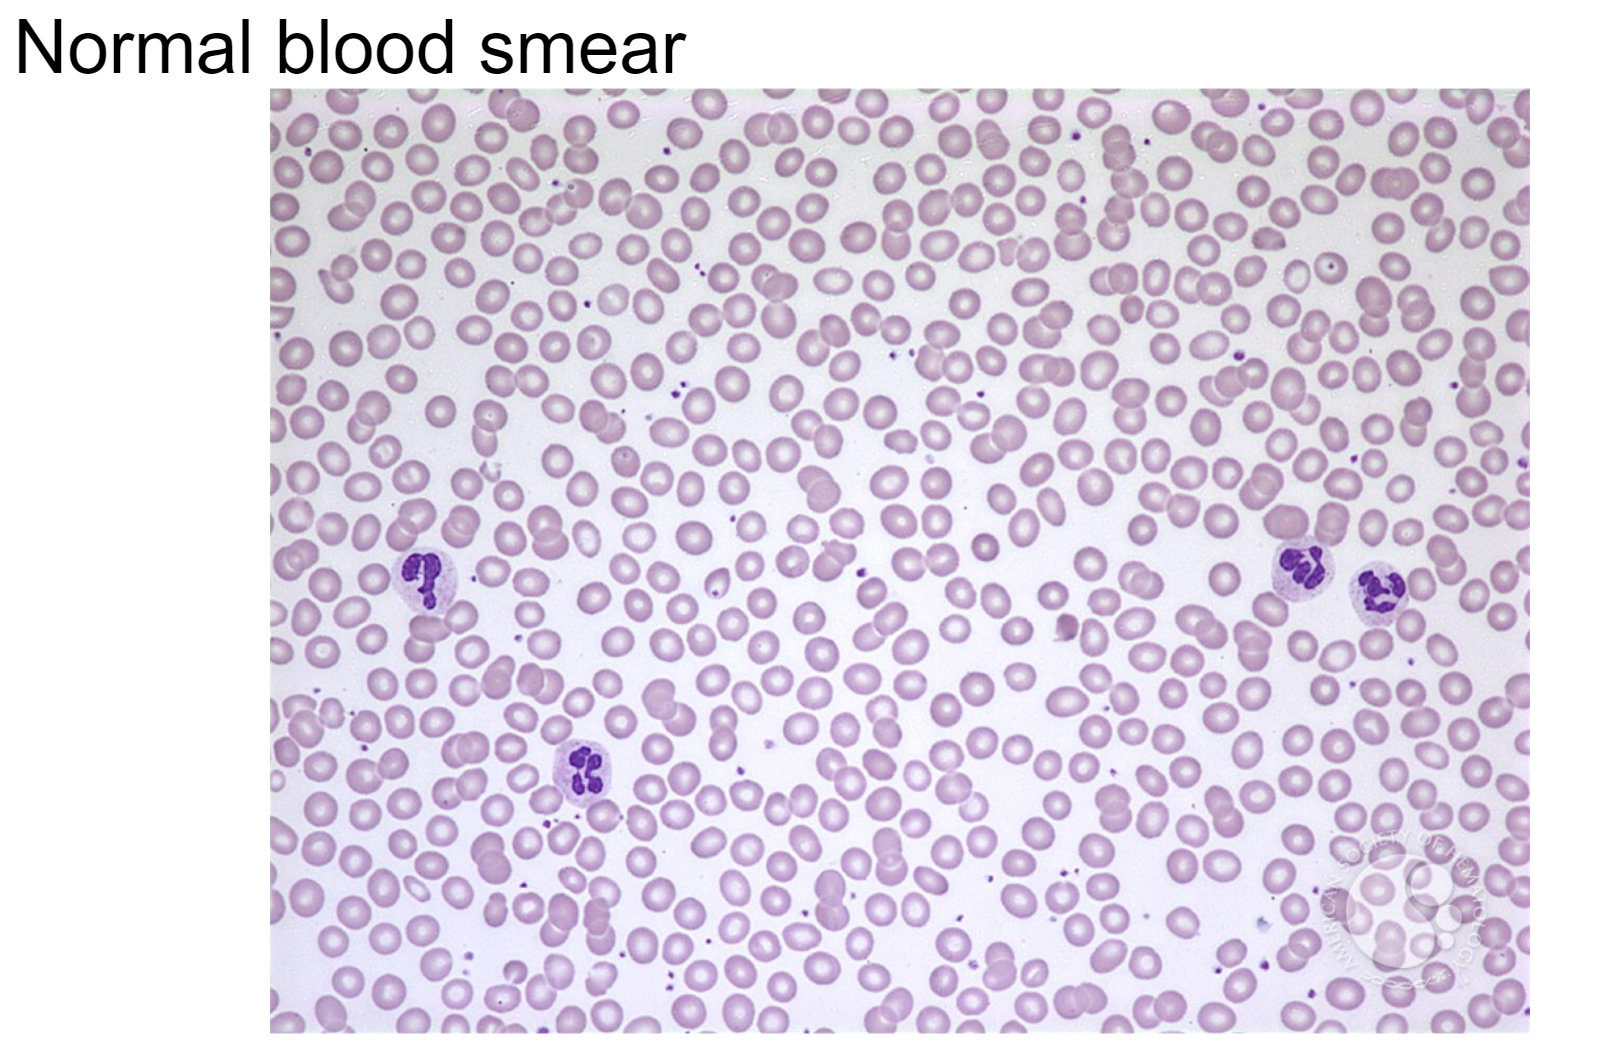
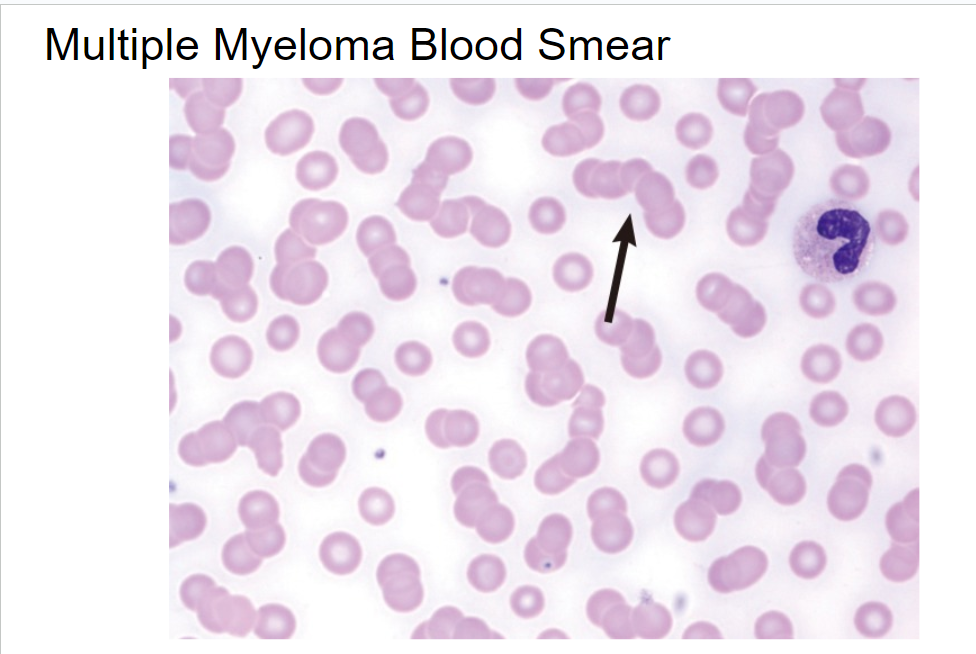
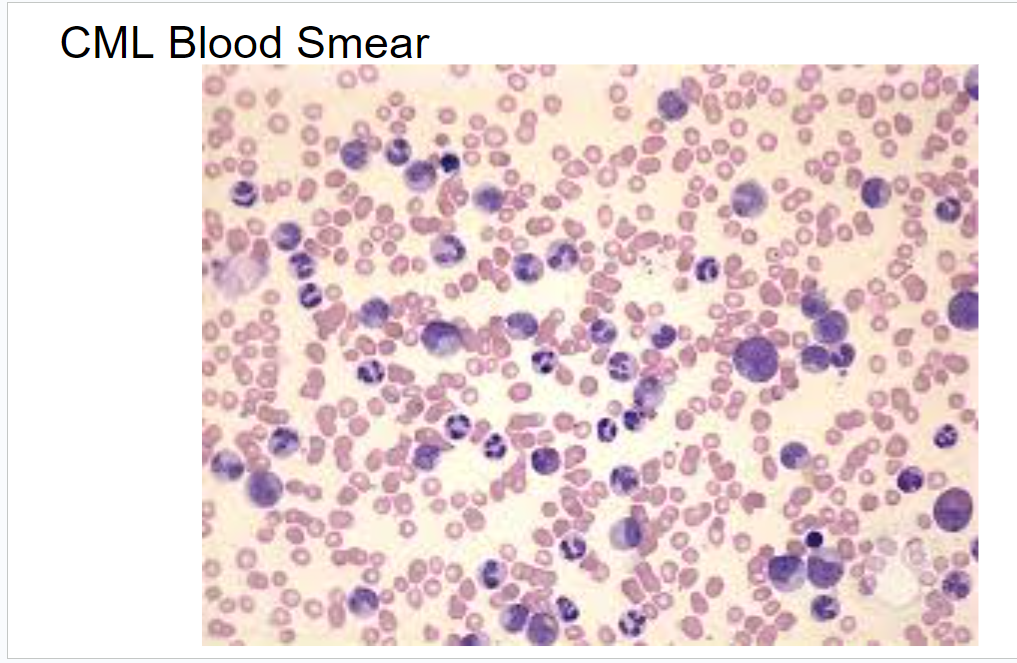

List some of Susan's symptoms
Part 1:
A Hectic Day
“OK, let’s get started on your homework while I make dinner. John Jr., can you help Mary with those math problems she has due tomorrow?”
“Sure. What’s for dinner, Grandma?”
I"’m making some chicken and vegetables. I already prepared it earlier so it won’t take long,” replied Susan.
John Jr. and Mary sat down on the living room floor, still wearing their jerseys, shorts, and high socks. It had been two years since their mother passed away from breast cancer, and they were still trying to adjust. Their father works at the local airport and has been on the night shift for the past five months. He was hoping to be back on days by next month so he didn’t have to rely on his mother to help out with the kids so much. It really seemed to be taking a toll on her. She was exhausted all the time now.
Susan sat down at the kitchen table after placing the chicken and vegetables in the oven to roast. She felt out of breath, even after just walking in from the car, helping the kids carry their school bags, and putting dinner in the oven. She used to walk three miles a day, but her job and personal life had become so hectic lately that she didn’t have the time or energy to exercise anymore. She had just turned 67, and felt that her age was finally catching up with her.
After checking the children’s homework and tucking them in, Susan washed the dishes, cleaned up the kitchen, and waited for her son to return from work. He walked in at about 11:30 p.m. and found her asleep on the couch. He nudged her awake.
“How’d it go today?” John asked.
“Fine. Mary hates fractions a little less than she did yesterday. John Jr. is still pretending to like my cooking, which is nice of him. They both had fun at their soccer practices.”
“Thanks for helping out so much. Hopefully I’ll be back on days soon so you won’t have this ridiculous schedule. How are you feeling? Do you still have that cold?” he asked.
“I just feel run down. But I’m not feverish anymore and I’m not sneezing or coughing. And for the last couple of weeks or so I’ve been waking up during the night with aches and pains.”
“That doesn’t sound good, Ma. Maybe you should see the doctor,” John suggested.
“I have an appointment with Dr. Owen next week, but I’m not sure what to tell him. I don’t feel well but I don’t really feel sick, either. I’ve been working longer hours because it’s tax season and you’ve been on nights. He’s probably going to tell me to get more rest. But I can’t. So the visit seems pointless.” Susan rubbed her eyes and yawned.
“Still, it’s better to get checked out. I’ll take the day off and go to the doctor with you.”
Why do you think Dr.Owen requested a CBC (complete blood count)?
What results to you expect to see in the CBC if Susan has an infection?
Why do you think Dr. Owen requested a blood smear?
Why do you think Dr. Owen requested a chest x-ray
The following week, Susan waited in the exam room for Dr. Owen to come in with her test results.
“Hello, Mrs. Forest. I’ve been looking over your test results. The blood count did come back abnormal. Your white blood cell count was elevated. This is something that can occur when someone has an infection, since these cells are involved in fighting disease. In addition, your red blood cell count was below normal. That would probably explain the shortness of breath you’ve been experiencing, since those cells are responsible for carrying oxygen around the body. However, it is your blood smear that concerns me. In addition to an elevated white blood cell count, many of your white blood cells are in the early stages of development—an immature state, if you will. This is something that occurs in cancers of the blood.”
“Oh my God! Are you saying you think I have cancer?” Susan gasped.
“Given your age and your symptoms, I believe that you have one of two types of blood
cancer—either multiple myeloma or chronic myeloid leukemia. Both of these are very treatable if detected early. I’ll need to perform some additional testing to determine your final diagnosis and treatment plan. In order to do this, I have to collect another blood sample and perform a bone marrow biopsy. This additional testing will also help to rule out an infection or other causes for the abnormal CBC.”
“So it might not be cancer?”
“We still can’t be sure, but you have to prepare yourself for that news. I can give you some
general information about these diseases, and we’ll also set up an appointment for you to have the bone marrow biopsy done at the hospital.”
“What is a bone marrow biopsy?”
“This is a test that is used to obtain a sample of bone marrow, the soft tissue in the center of the bones. We use a needle to remove a small sample of those cells. You’ll receive an injection to the area to numb you.”
“Will the removal of the cells hurt?”
“The initial injection of the numbing agent causes a sharp sting. Once the larger needle is
inserted, the center of it is removed and a core of bone marrow is collected. Some patients report feeling a dull pain during the collection, since the numbing agent is not injected into the bone. However, not all patients report pain during the procedure.”
“Why do you need bone marrow if I am giving another blood sample anyway?”
What were Susan's test results?
What are some signs and symptoms of multiple myeloma?
What are some signs and symptoms of chronic myeloid leukemia?

What do you notice about Susan's blood smear? A normal blood smear is provided for comparison.

In multiple myeloma blood smear the red blood cells are clumped together. Does this look similar to Susan's blood smear?
The CML blood smear contains a lot of white blood cells (larger darker purple spots). Does this look similar to Susan's blood smear?
“Well, in chronic myeloid leukemia a very specific mutation is present in the DNA of the bone marrow cells. This mutation, or change in the DNA, is usually detectable in the blood also.”
“What is this mutation?”
“It is generally referred to as the Philadelphia chromosome. The DNA in your cells is organized into smaller ‘pieces’ called chromosomes. Humans have 23 pairs of chromosomes. In CML, chromosome 9 and chromosome 22 exchange pieces, resulting in an abnormal gene. This gene produces the protein BCR-ABL tyrosine kinase.”
“What the heck is that?”
“Tyrosine kinases are involved in regulating the cell cycle and often cause cells to proliferate,
or make more cells. The normal form of the protein has no harmful effects, but this abnormal form caused by the chromosomal translocation results in higher rates of cell proliferation, which leads to cancer. I am going to perform two tests on the bone marrow. One, called karyotyping, involves examining the chromosomes present in the bone marrow cells to determine whether the Philadelphia chromosome is present. Another test,
called Real-time Quantitative PCR (RQ-PCR), determines whether this abnormal form of the gene is producing the BCR-ABL tyrosine kinase. This will help us in deciding what course of treatment to take if you do, in fact, have CML.”
Why is Dr. Owen going to perform a karyotype?
“Well, Mrs. Forest, I’ve examined all of your test results and concluded that you are suffering from chronic myeloid leukemia. I’m sorry to have to bring you this news. However, I will reassure you that this particular type of cancer is very treatable due to recent advances in leukemia research,” Dr. Owen reported.
“Do I have to go for radiation treatment?”
“That is generally not the recommended first course of treatment for this type of cancer. Since we know that the abnormal BCR-ABL tyrosine kinase is present in your bone marrow cells, your treatment will focus on disabling this protein in order to stop the growth of the cancer cells.”
“I don’t understand how the treatment can just target one thing.”
“Well, the standard treatment for CML involves taking a drug called imatinib. This is a
substance that inhibits that mutant protein we spoke about last time, BCR-ABL. Since BCR- ABL causes increased cell growth, when imatinib binds to and inhibits it, the cells stop growing. This markedly reduces the cancer growth and leads to remission in the vast majority of patients. Obviously nothing is guaranteed, but your prognosis is quite good.”
“How long do I have to take the drug? Are there side effects?”
“You will likely need to remain on the drug even after you are in remission. It seems that
interruption of treatment usually results in a relapse.”
“I have to take this drug for the rest of my life?”
“It’s possible, and we’ll have to continue to monitor your blood counts and BCR-ABL levels even while you are being treated, to make sure the drug is working.”
“What about side effects?” Susan was particularly concerned about this, since she had witnessed the side effects of chemotherapy and radiation when her daughter-in-law was sick.
“My daughter-in-law lost her hair and had terrible nausea, to the point where she couldn’t even take care of the kids. It was awful,” Susan continued, “and I need to be able to continue working and helping my son...”
“Well, the side effects of imatinib are not as severe as what you see with traditional
chemotherapy and radiation. In fact, most patients find the side effects mild enough to continue using imatinib. The benefit of reducing CML cells outweighs the risks. Most commonly, patients report edema, or fluid retention. This is particularly common in patients over 65, so that is a concern for you. We have to continue regular blood counts to monitor you for anemias. Also, it is common for patients to experience some nausea, joint pain, or muscle cramps. Bleeding, hypothyroidism, and hepatotoxicity (damage to the liver) are less common but can occur as well.”
“So this type of cancer—it seems like it never really goes away?”
“CML is what is referred to as a chronic form of leukemia. It is not an aggressive cancer, and most people respond very well to treatment, as I said. But even when a patient is in remission we have to keep monitoring you and treating you because small numbers of cancer cells can still be present in the cells of the bone marrow. The only real cure for CML is a bone marrow transplant, but if you respond well to imatinib we won’t have to do that. A bone marrow transplant is much more invasive than taking a pill, and it is difficult to find a donor. So we only do that if the patient does not respond to drug treatment.”
“If I don’t respond to the imatinib, I’ll have to get a bone marrow transplant?” inquired Susan.
“No, not necessarily. There are other drugs besides imatinib that act as tyrosine kinase
inhibitors. They are not as effective as imatinib and may have more side effects. So we start first with imatinib, then move on to other tyrosine kinase inhibitors if necessary. The bone marrow transplant is a last resort for patients who don’t respond to any drug treatments. But let’s not get ahead of ourselves—we should see if the imatinib works for you first.”
“What about my job? And my grandchildren?”
“You’ll have to make some adjustments to your lifestyle, particularly during your treatment. Until you return to feeling well, you’ll need to reduce your activity levels for a while. Though I encourage you to stay physically active if you are feeling up to it, since that is generally beneficial.”
“Should my son or my grandchildren be tested to see if they are at risk for CML? Does this
mean cancer runs in our family now?”
“CML is caused by a random mutation in the bone marrow later in life and is considered sporadic. It’s not like other forms of cancer that run in families, so you don’t have to worry about that.”
“OK. I don’t think I have any more questions right now. So what do I do next? I feel like I should get a second opinion for something this serious.”
“I’ll send you to a CML specialist to get a second opinion. After you see him, we’ll meet again to discuss the start of your treatment.”
“Thank you, Dr. Owen.”
“And they also have some information at the front desk on support groups for
patients with CML. Sometimes it can be helpful to speak with others who
are going through the same thing.”
Part 2:
A Visit to the Doctor
Susan sat nervously in Dr. Owen’s office. “I hate going to the doctor,” she said to her son. She fidgeted in her chair. “And I feel so silly coming in when I’m not even that sick.”
“It can’t hurt to have him examine you, Mom. Just relax,” replied John.
“Susan Forest?” the nurse asked.
Susan followed the nurse into the small exam room and sat on the crunchy white paper waiting for Dr. Owen. He walked in and shook her hand.
“What brings you here today, Mrs. Forest?”
“I haven’t been feeling well lately. I had a cold for a while that never seemed to completely get better, and I’ve been feeling tired and achy for a while. I’ve also been extremely busy at work and watching my grandchildren, so I think it’s just lack of sleep. But recently I’ve been waking up at night with pain.”
“OK, Mrs. Forest. I’m going to do a history and physical right now. I’ll ask you some questions about your symptoms, your general medical history, and your lifestyle, and then I’ll perform a physical exam to try to determine what is causing your symptoms. How old are you, Mrs. Forest?”
“Sixty-seven,” she replied.
“And how long ago did you begin having symptoms?”
“About three months ago, in February, I caught a cold that I couldn’t seem to get rid of.”
“Are you still producing mucus when you cough or sneeze? Are you blowing your nose a lot?”
“Not anymore.”
“Did you take any over-the-counter medications?”
“Yes, for about two weeks I took an over-the-counter decongestant and pain reliever.”
“So at that point you weren’t really having the cold symptoms anymore?”
“Right.”
“What about fevers? Did you take your temperature?”
“No, but I felt feverish once in a while even after the cold symptoms stopped. I don’t think it was a very high fever, though.”
“And you said you are feeling tired a lot. How much sleep do you usually get each night?”
“About five or six hours every night, which I don’t feel is enough.”
“Why do you think you aren’t getting enough sleep?”
“Well, I work in an accountant’s office, so tax season is our busiest time. In early March I started working about 60 hours per week. Also, my son started working the night shift a little after that, and that’s when I began picking up my grandchildren after their sports practices and watching them until their father gets home.”
“Any shortness of breath after activities?”
“As a matter of fact, yes. I’ve been exercising a lot less than usual because I become out of
breath. Even after just cleaning...”
“Have you been around anyone who was sick with the flu or any other contagious illness?”
“I don’t think so. No one at work or in my family has been sick.”
“Have you had any nausea or diarrhea or stomach upset in general?”
“No.”
“Have you been urinating more frequently or had blood or pain with urination?”
“No.”
“You said you’ve been having pain at night? Is this only at night, or do you feel pain upon waking up in the morning?”
“Only during the night.”
“Does the pain wake you from sleep?”
“Yes, sometimes.”
“Is the pain localized in one specific place?”
“No, it’s just general achiness, almost like my bones hurt. Sometimes it’s in my upper legs,
sometimes my back hurts. But I can’t pinpoint it to one location.”
“Do you find that the pain increases with more activity?”
“No, not really.”
“Have you lost any weight?”
“No.”
“Do you or any close family members have high blood pressure, diabetes, cancer, or heart disease?”
Susan shook her head. “No. My daughter-in-law died of breast cancer, but none of my blood relatives have had it. My grandmother had diabetes, but no one else who I know of has had anything else you mentioned.”
“Do you smoke or drink alcohol? Are you taking any drugs or prescription medications?”
“No, I don’t smoke or drink. I have a prescription medication for migraine headaches, but only take it when I get a migraine, which is usually about once a month or so. I don’t take any other medicines, and I don’t use any illegal drugs for heaven’s sake.”
“OK. I have to ask these questions just so I can get a clear picture of your overall health.”
Upon physical examination, Dr. Owen noticed that Susan’s spleen, located under the ribs on the left side of the abdomen, was swollen.
“I think that we should run some tests, so I’m going to take a blood sample from you. I am
requesting a CBC (complete blood count) with differential. This will determine your hemoglobin and hematocrit levels, which are proteins present in the blood. It will also give me your platelet count, red blood cell count, and white blood cell count (including the percentage of each type of white blood count). All of these cells are present at specific levels in the blood of healthy individuals but can increase or be reduced when someone is sick. I am also requesting a blood smear—meaning the lab technicians will look at your blood sample under a microscope—and a chest X-ray. I should have the results in a few days. My office will call you to schedule a follow-up appointment as soon as we have the results.”
“Thank you, Dr. Owen. Do you think this is something serious?”
“I can’t really say until I have more information. Let’s wait and see what the results of the blood work tell us.”
What part of blood transports oxygen?
What part of blood helps fight infections?
What part of blood helps with blood clotting?
Chronic myeloid leukemia has a very specific mutation known as the
In CML, what two chromosomes exchange pieces resulting in an abnormal gene?
What gene does the Philadelphia chromosome produce?
What are tyrosine kinases are involved in ?
Real-time Quantitative PCR test will determine if the abnormal form of the Philadelphia chromosome is producing the BCR-ABL tyrosine kinase.
How do you think Susan’s diagnosis will affect her lifestyle? What changes
will she have to make?
What do treatments of CML focus on?
What are some side effects of imatinib?
What are some advantages and disadvantages of a bone marrow transplant?
Are Susan's grandchildren at risk for CML?